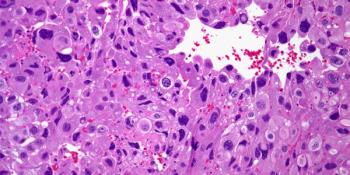
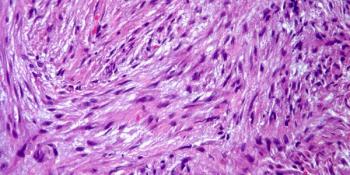
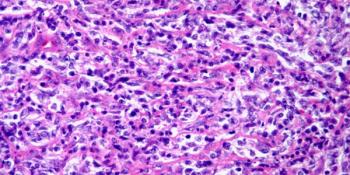
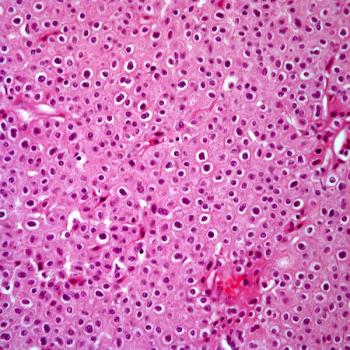
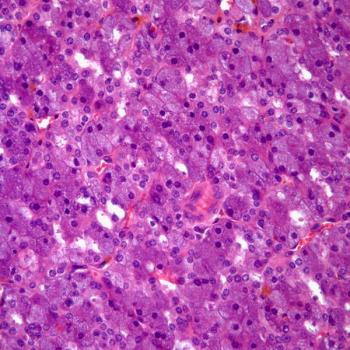
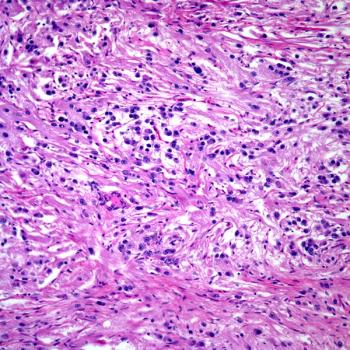

A 36-year-old man presents with a painless right arm mass. What is your diagnosis?

A 36-year-old man presents with a painless right arm mass. What is your diagnosis?

A 48-year-old woman presents with a mass in the right kidney. What is your diagnosis?

A 23-year-old patient is found to have a “lump” on the left clavicle during a routine physical exam. Resection of the lump was performed. What is your diagnosis?
A 27-year-old woman, postpartum, presents with vaginal bleeding. What is your diagnosis?
A 28-year-old woman presents with a 2-cm nodule on her left arm. What is your diagnosis?

A 52-year-old woman presents with a right kidney mass. What is your diagnosis?

A 68-year-old man presents with a dark lesion on his forehead. A surgical resection is performed. What is your diagnosis?
A 63-year-old man presents with pain in the right arm. A lesion in the humerus is identified and a biopsy is taken. What is your diagnosis?

A 28-year-old man presents with a mass in his right testicle. What is your diagnosis?

A 57-year-old man presents with symptoms of pain in the sacral area. A mass is resected. What is your diagnosis?

A 63-year-old woman presents with a lesion of the oral mucosa, located behind the lip. Resection of the lesion is performed. What is your diagnosis?

A biopsy is taken from the prostate of a 67-year-old man. What is your diagnosis?

A 47-year-old man presents with a lesion in the ascending ramus of the mandible. A resection of the lesion is performed. What is your diagnosis?

A 67-year-old man presents with a lower leg mass close to his Achilles tendon. What is your diagnosis?

A 45-year-old woman presents with a back mass. What is your diagnosis?

A 58-year-old man presents with a left kidney mass. What is your diagnosis?

A 58-year-old smoker with recurrent pneumonia presents with an ill-defined mass in the right lung. What is your diagnosis?

A 48-year-old woman presents with a left kidney mass. What is your diagnosis?
A 56-year-old man presents with a left kidney mass. What is your diagnosis?
A 57-year-old man presents with swelling of the left neck. Surgical resection of a mass is performed. What is your diagnosis?
A 7-year-old patient is found to have a posterior mediastinal mass. Surgical resection of the mass is performed. What is your diagnosis?

A 53-year-old woman presents with a left kidney mass. What is your diagnosis?

A 34-year-old woman presents with swelling on the right side of her neck. A resection of the mass is performed. What is your diagnosis?

A 54-year-old man presents with a nodule on his back. A resection is performed. What is your diagnosis?



A 61-year-old woman presents with symptoms of shortness of breath and a cough of several weeks duration. Chest imaging reveals the presence of an intrapulmonary mass. What is your diagnosis?

A 17-year-old boy presents with pain in the right hip. What is your diagnosis?

A 50-year-old man presents with a reddish mass at the limbus of his right eye. What is your diagnosis?

A 78-year-old man presents with a cough and history of weight loss of several weeks' duration. Chest imaging reveals the presence of an intrapulmonary mass. What is your diagnosis?